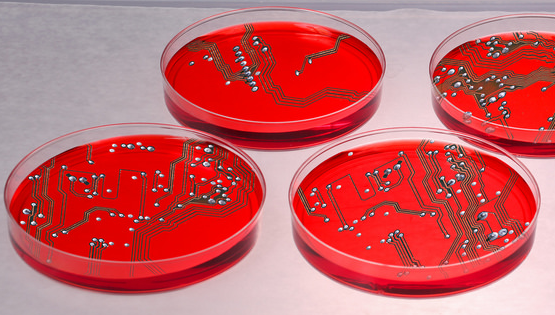

Executive Coaching
for Technical Leaders

Executive Coaching for Leaders and Founders
The technical challenges are often the easy part of your role, but leading people and teams can be hard. I’ll help you connect with your team, lead authentically, and level up.

Peer Learning
Circles
I lead learning circles to help you connect with leaders facing similar challenges, offer advice, share experiences, and build relationships
in a collaborative environment of continuous learning.

Resources, Newsletter, and Community
My Continuous Growth newsletter is your source for leadership and career growth solutions. Coaching clients get lifetime access, or become a paid member to access all benefits including access to live podcasts and events, hours of video recordings, and a private leadership networking community.

I support leaders at all scales from startup to enterprise






Building and leading
high-performance
teams.

I implemented the Lean Startup methodologies with Eric Ries as VP of Engineering and Operations at IMVU (literally the first Lean Startup), where my team helped start the DevOps movement and coined the term “continuous deployment.” I have more than two decades of experience as a Founder, Director, and VP of Engineering leading high-performance teams in startups including There.com, IMVU, SmugMug, and Caffeine, and within scaled organizations including Amazon.

Courses
Accelerate Your Tech Teams: Coaching Modes for Technical Leaders using CAMS
Master the four modes of technical leadership development for your team using CAMS, and know exactly when to Coach, Advise, Mentor, or Support your team.
Self-Awareness for Leaders
Self-awareness is the basis of great leadership and your capacity to adopt a growth mindset. I’ll show you how to develop your practice of self-awareness to support your team and your career.
The Cognitive Science Behind Your Brain’s OS
Understanding how your brain interprets data and is influenced by your traits and life experience will help find your power and truly author your experience.
And events
September 11, 2025
Your Human Advantage in an AI World: ELC Annual Conference 2025

This session defined the 2025 Leadership theme at ELC, and addresses the core paradox of AI-era leadership: while AI technology evolves rapidly, self-awareness as the foundation of human leadership becomes MORE critical, not less. As AI handles increasing technical execution, leaders who master self-awareness—understanding their own Leadership OS and upgrading it systematically—will drive innovation and create the foundation for successful AI adoption.
August 14, 2025
Why Founders Should Invest in Coaching, Communication, and Leadership Before You Scale : The Engineering Founders Podcast

Founders often delay leadership coaching until a major crisis hits, leading to significant costs in productivity, team churn, and poor decisions. In this episode with Patrick Gallagher of ELC, I argue that early coaching is a game-changer for a startup’s success. We explore the hidden costs of waiting and the benefits of intentionally installing leadership and communication systems before you scale.
January 7, 2025
The Four Modes of Coaching + Navigating Career Growth In Expanding and Contracting Companies: The Engineering Leadership Podcast

Listen in as I chat with Patrick Gallagher of ELC about coaching, technical advising, and my technical leadership journey spanning tiny startups during DotCom 1.0 through to my technical advisory role at Amazon.
August 27, 2024
ELC Annual Conference 2024
Coaching: Directive vs. Non-Directive Approaches to Support Your Teams’ Success

As engineering leaders one of our most important responsibilities is to support our people, and one way we do that is through coaching and mentoring. In this roundtable I led discussion of challenges leaders are facing related to coaching and mentoring, and shared our collective insights to help each other learn and grow our coaching and mentoring practice. I shared and led discussions on frameworks and approaches for coaching, mentoring, advising, and supporting.
Nov 5, 2020
Fireside Chat – ELC Annual Conference 2020
Engineering Resilience: A Case Study Of Super Bowl 2020 Live Streaming By Fox

Super Bowl 2020 set a new record for peak concurrent live streams while also offering the content at a new quality bar – UHD HDR – for the first time. For Fox Sports, this meant 5X’ing its previous platform record on the highest stakes day of the year when several things broke, but customers never knew! Join me as I chat with Melody Hildebrandt, EVP of Engineering at FOX and share lessons learned from preparations to deliver this event digitally – from architecting a highly scalable API tier to aligning 20+ technology partners against a common objective.
Start your journey
Book a free consultation.
Schedule your free consultation and find out how mindset coaching can help you.